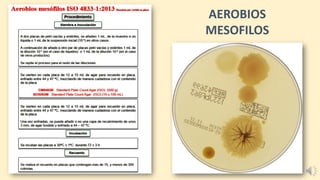
AEROBIOS
MESOFILOS
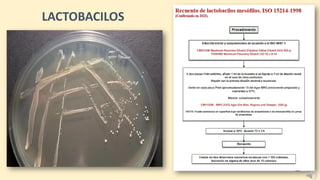
LACTOBACILOS
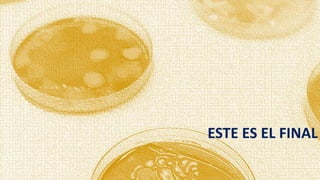
ESTE ES EL FINAL

El documento aborda la microbiología en la producción de bebidas fermentadas, enfocándose en la importancia de la zonificación higiénica y el monitoreo ambiental para prevenir la contaminación microbiana. Se discuten los métodos de muestreo y control de patógenos, así como los criterios de higiene y los riesgos asociados a contaminantes en la elaboración de cerveza. También se mencionan las especificaciones sobre microorganismos y la estabilidad microbiológica de la cerveza, destacando la relevancia de una adecuada limpieza y sanitación en el proceso.